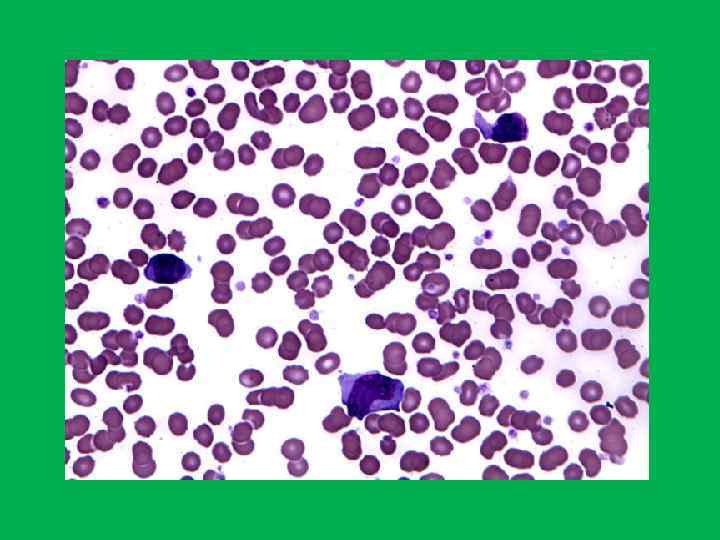

Мононуклеоз.ppt
- Количество слайдов: 17
 Инфекционный мононуклеоз
Инфекционный мононуклеоз
 Инфекцио нный мононуклео з нный • (mononucleosis infectiosa, боле знь Фила това, анги на моноцита рная, това, на рная, лимфобласто з доброка чественный) — чественный) острое вирусное заболевание, которое характеризуется лихорадкой, поражением зева, лимфатических узлов, печени, селезенки и своеобразными изменениями состава крови.
Инфекцио нный мононуклео з нный • (mononucleosis infectiosa, боле знь Фила това, анги на моноцита рная, това, на рная, лимфобласто з доброка чественный) — чественный) острое вирусное заболевание, которое характеризуется лихорадкой, поражением зева, лимфатических узлов, печени, селезенки и своеобразными изменениями состава крови.
 История • Н. Ф. Филатов (1895), первым обратил внимание на лихорадочное заболевание с увеличением лимфатических узлов и назвал его идиопатическим воспалением лимфатических желез. Описанное заболевание долгие годы носило его имя — болезнь Филатова. • В 1889 г. немецкий ученый Е. Пфейффер описал аналогичную клиническую картину заболевания и определил его как железистую лихорадку с поражением зева и лимфатической системы.
История • Н. Ф. Филатов (1895), первым обратил внимание на лихорадочное заболевание с увеличением лимфатических узлов и назвал его идиопатическим воспалением лимфатических желез. Описанное заболевание долгие годы носило его имя — болезнь Филатова. • В 1889 г. немецкий ученый Е. Пфейффер описал аналогичную клиническую картину заболевания и определил его как железистую лихорадку с поражением зева и лимфатической системы.

 • С введением в практику гематологических исследований были изучены характерные изменения состава крови при этом заболевании, в соответствии с которыми американские учёные Т. Спрент и Ф. Эванс назвали заболевание инфекционным мононуклеозом. • В 1964 г М. А. Эмпштейн и И. Барр выделили из клеток лимфомы Беркитта герпесоподобный вирус, названный в их честь вирусом Эмпштейна-Барр, который позднее с большим постоянством обнаруживали при инфекционном мононуклеозе.
• С введением в практику гематологических исследований были изучены характерные изменения состава крови при этом заболевании, в соответствии с которыми американские учёные Т. Спрент и Ф. Эванс назвали заболевание инфекционным мононуклеозом. • В 1964 г М. А. Эмпштейн и И. Барр выделили из клеток лимфомы Беркитта герпесоподобный вирус, названный в их честь вирусом Эмпштейна-Барр, который позднее с большим постоянством обнаруживали при инфекционном мононуклеозе.
 Эпидемиология • Источником инфекции являются больной человек, в том числе со стертыми формами болезни, и вирусоноситель. • От больного человека к здоровому возбудитель передается воздушно-капельным путём, чаще всего со слюной (например, при поцелуе, отсюда название «поцелуйная болезнь» , при использовании общей посуды, белья, постели и т. п. ), возможна передача инфекции при переливании крови. • Заражению способствуют скученность и тесное проживание больных и здоровых людей, поэтому нередки вспышки заболевания в общежитиях, интернатах, лагерях, детских садах.
Эпидемиология • Источником инфекции являются больной человек, в том числе со стертыми формами болезни, и вирусоноситель. • От больного человека к здоровому возбудитель передается воздушно-капельным путём, чаще всего со слюной (например, при поцелуе, отсюда название «поцелуйная болезнь» , при использовании общей посуды, белья, постели и т. п. ), возможна передача инфекции при переливании крови. • Заражению способствуют скученность и тесное проживание больных и здоровых людей, поэтому нередки вспышки заболевания в общежитиях, интернатах, лагерях, детских садах.
 Этиология • Возбудитель - ДНК-геномный вирус рода Lymphocryptovirus подсемейства Gammaherpesvirinae семейства Herpesviridae. • Вирус способен реплицироваться, в том числе в В-лимфоцитах; в отличие от других вирусов герпеса он не вызывает гибели клеток, а напротив, активирует их пролиферацию.
Этиология • Возбудитель - ДНК-геномный вирус рода Lymphocryptovirus подсемейства Gammaherpesvirinae семейства Herpesviridae. • Вирус способен реплицироваться, в том числе в В-лимфоцитах; в отличие от других вирусов герпеса он не вызывает гибели клеток, а напротив, активирует их пролиферацию.
• Вирионы включают специфические антигены: капсидный (VCA), ядерный (EBNA), ранний (ЕА) и мембранный (МА) антигены. Каждый из них образуется в определённой последовательности и индуцирует синтез соответствующих антител. В крови больных инфекционным мононуклеозом сначала появляются антитела к капсидному антигену, позднее вырабатываются антитела к ЕА и МА. Возбудитель малоустойчив во внешней среде и быстро гибнет при высыхании, под действием высокой температуры и дезинфектантов.
• Вирионы включают специфические антигены: капсидный (VCA), ядерный (EBNA), ранний (ЕА) и мембранный (МА) антигены. Каждый из них образуется в определённой последовательности и индуцирует синтез соответствующих антител. В крови больных инфекционным мононуклеозом сначала появляются антитела к капсидному антигену, позднее вырабатываются антитела к ЕА и МА. Возбудитель малоустойчив во внешней среде и быстро гибнет при высыхании, под действием высокой температуры и дезинфектантов.
 Инкубационный период • может достигать до 21 дня, обычно составляет около недели. Период болезни до двух месяцев
Инкубационный период • может достигать до 21 дня, обычно составляет около недели. Период болезни до двух месяцев
 Симптомы • слабость • слизь в легких • частые головная боль, мигрень, головокружения • боль в мышцах и суставах (чаще всего от оказываемого давления со стороны образовавшей узлы лимфы; чем больше узел, тем большее давление может оказываться на нервные окончания)
Симптомы • слабость • слизь в легких • частые головная боль, мигрень, головокружения • боль в мышцах и суставах (чаще всего от оказываемого давления со стороны образовавшей узлы лимфы; чем больше узел, тем большее давление может оказываться на нервные окончания)

 • повышение температуры тела (как следствие - повышенное потоотделение) • боли в горле при глотании (ангина) • воспаление и увеличение лимфатических узлов (без медикаментозного вмешательства в течение болезни на протяжении длительного периода времени (несколько месяцев/лет) наблюдается не только качественное увеличение уже воспаленных лимфоузлов, но и увеличение их числа , например, вялотекущее преобразование одного узла в цепочку из трех) • увеличение печени и/или селезёнки
• повышение температуры тела (как следствие - повышенное потоотделение) • боли в горле при глотании (ангина) • воспаление и увеличение лимфатических узлов (без медикаментозного вмешательства в течение болезни на протяжении длительного периода времени (несколько месяцев/лет) наблюдается не только качественное увеличение уже воспаленных лимфоузлов, но и увеличение их числа , например, вялотекущее преобразование одного узла в цепочку из трех) • увеличение печени и/или селезёнки

 • появление в крови атипичных мононуклеаров, увеличение доли одноядерных элементов (лимфациты, моноциты) • увеличение чувствительности к ОРВИ и прочим респираторным заболеваниям • частые поражения кожного покрова вирусом Herpes simplex virus ( «простой герпес", или вирус герпеса первого типа), обычно в области верхней или нижней губы
• появление в крови атипичных мононуклеаров, увеличение доли одноядерных элементов (лимфациты, моноциты) • увеличение чувствительности к ОРВИ и прочим респираторным заболеваниям • частые поражения кожного покрова вирусом Herpes simplex virus ( «простой герпес", или вирус герпеса первого типа), обычно в области верхней или нижней губы
 Осложнения • Отиты • Паратонзиллиты • Синуситы • Пневмония • Редко: разрыв селезёнки, острая печёночная недостаточность, острая гемолитическая анемия, невриты.
Осложнения • Отиты • Паратонзиллиты • Синуситы • Пневмония • Редко: разрыв селезёнки, острая печёночная недостаточность, острая гемолитическая анемия, невриты.
 Лечение • • • Специфическая терапия не разработана. Лечение симптоматическое, общеукрепляющее. Из-за риска разрыва селезенки рекомендовано ограничение физической нагрузки в первые 1 -1, 5 месяца. • Для снижения температуры лучше использовать парацетамол, так как применение аспирина может провоцировать синдром Рея. • Противовирусное лечение — ацикловир таблетки 0, 1 (детям до 3 х лет), 0, 2 (старше 3 х лет) — 5 раз в день или циклоферон по схеме. • Рекомендуется одеваться теплее.
Лечение • • • Специфическая терапия не разработана. Лечение симптоматическое, общеукрепляющее. Из-за риска разрыва селезенки рекомендовано ограничение физической нагрузки в первые 1 -1, 5 месяца. • Для снижения температуры лучше использовать парацетамол, так как применение аспирина может провоцировать синдром Рея. • Противовирусное лечение — ацикловир таблетки 0, 1 (детям до 3 х лет), 0, 2 (старше 3 х лет) — 5 раз в день или циклоферон по схеме. • Рекомендуется одеваться теплее.


